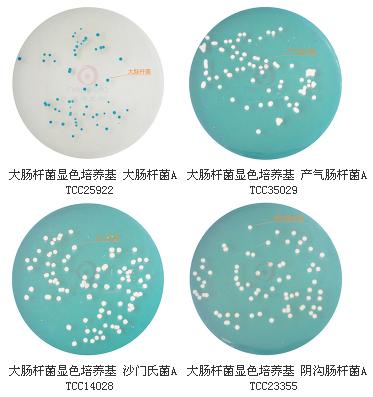
大腸桿菌顯色培養基9cm

大腸桿菌顯色培養基9cm(2-8℃)
貨號:VIP(HB)PM7001
規格:9cm*10個/包
用途:用于食品、水、牛奶、冰激凌和肉制品中大腸桿菌的快速檢測。大腸桿菌顯藍綠色,大腸菌群顯無色,其它菌顯黃色或無色,革蘭氏陽性菌被抑制。
大腸桿菌顯色培養基9cm成份(g/L)

操作步驟
1、按國家標準、SN標準、FDA標準或其它方法制備樣品液;
2、取樣品液 1ml 加入冷卻至 45-50℃ 顯色培養基中混勻或涂布于平板上;
3、36℃ 培養18~24h,選用有 30~200 個菌落的平板,計數平板上出現的典型大腸桿菌菌落。大腸桿菌典型菌落為藍綠色,其它細菌為無色或黃色菌落。
總大腸桿菌=藍綠色菌落;
4、對可疑大腸桿菌菌落可劃線接種到營養瓊脂平板上,36℃ 培養 12-16 小時,挑取單菌落做大腸桿菌全套生化試驗(本公司有生化鑒定管套裝 4種x4套)。
質量控制
1、外觀
平板呈透明無色固體培養基。
2、微生物試驗
在 36℃ 培養 18~24h 小時:
方法的局限性
本培養基鑒定大腸桿菌,少數情況下可能會出現假陽性,但不會出現假陰性,有時可能需做其它補充試驗。
典型特征
大腸桿菌典型菌落為藍綠色,大腸菌群為無色菌落,其它細菌為無色或黃色菌落。
大腸桿菌顯色培養基的微生物靈敏度試驗:
按標簽用法制備培養基,接種以下質控菌株,放置36±1℃需氧培養18-24小時。
注:回收率計算時,用TSA瓊脂做對照培養基。

聲明:此對照品、標準品由中檢計量:提供網站查詢購買服務
注:點擊cas,或者搜索:名稱、編號、cas均可顯示價格